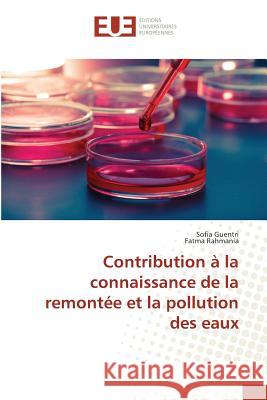
Contribution À La Connaissance de la Remontée Et La Pollution Des Eaux Sans Auteur 9783841673725 Editions Universitaires Europeennes - książka

Contribution À La Connaissance de la Remontée Et La Pollution Des Eaux » książka
Contribution À La Connaissance de la Remontée Et La Pollution Des Eaux
ISBN-13: 9783841673725 / Francuski / Miękka / 2018 / 108 str.
Les regions du Sud algerien et particulierement la region de Oued Souf sont confrontees au phenomene de la remontee des eaux qui se manifeste par une pollution et une degradation de l'environnement. Les ghouts sont des depressions, creusees par l'homme, pour permettre aux racines des palmiers d'etre proches de la nappe phreatique. L'objectif de notre travail est de tenter de connaitre la pollution minerale et microbiologique dans les eaux des ghouts et, egalement, de tester la capacite de resistance aux metaux lourds (Cd, Pb et Cu) de certaines souches bacteriennes isolees des biotopes pollues. Les resultats des analyses physico-chimiques ont montre une pollution apparente dans les sites d'etude; quant aux analyses microbiologiques nous avons pu isoler une cinquantaine de souches bacteriennes reparties sur 13 genres. Les souches fongiques appartiennent a 5 genres, les cyanobacteries et les micro-algues sont reparties sur 8 genres. Pour etudier leurs comportements en presence de metaux lourds (Cd, Pb et Cu), deux souches bacteriennes, Aeromonas sp. et Staphylococcus xylosus ont ete choisies pour les tests.
Les régions du Sud algérien et particulièrement la région de Oued Souf sont confrontées au phénomène de la remontée des eaux qui se manifeste par une pollution et une dégradation de lenvironnement. Les ghouts sont des dépressions, creusées par lhomme, pour permettre aux racines des palmiers dêtre proches de la nappe phréatique. Lobjectif de notre travail est de tenter de connaître la pollution minérale et microbiologique dans les eaux des ghouts et, également, de tester la capacité de résistance aux métaux lourds (Cd, Pb et Cu) de certaines souches bactériennes isolées des biotopes pollués. Les résultats des analyses physico-chimiques ont montré une pollution apparente dans les sites détude ; quant aux analyses microbiologiques nous avons pu isoler une cinquantaine de souches bactériennes réparties sur 13 genres. Les souches fongiques appartiennent à 5 genres, les cyanobactéries et les micro-algues sont réparties sur 8 genres. Pour étudier leurs comportements en présence de métaux lourds (Cd, Pb et Cu), deux souches bactériennes, Aeromonas sp. et Staphylococcus xylosus ont été choisies pour les tests.